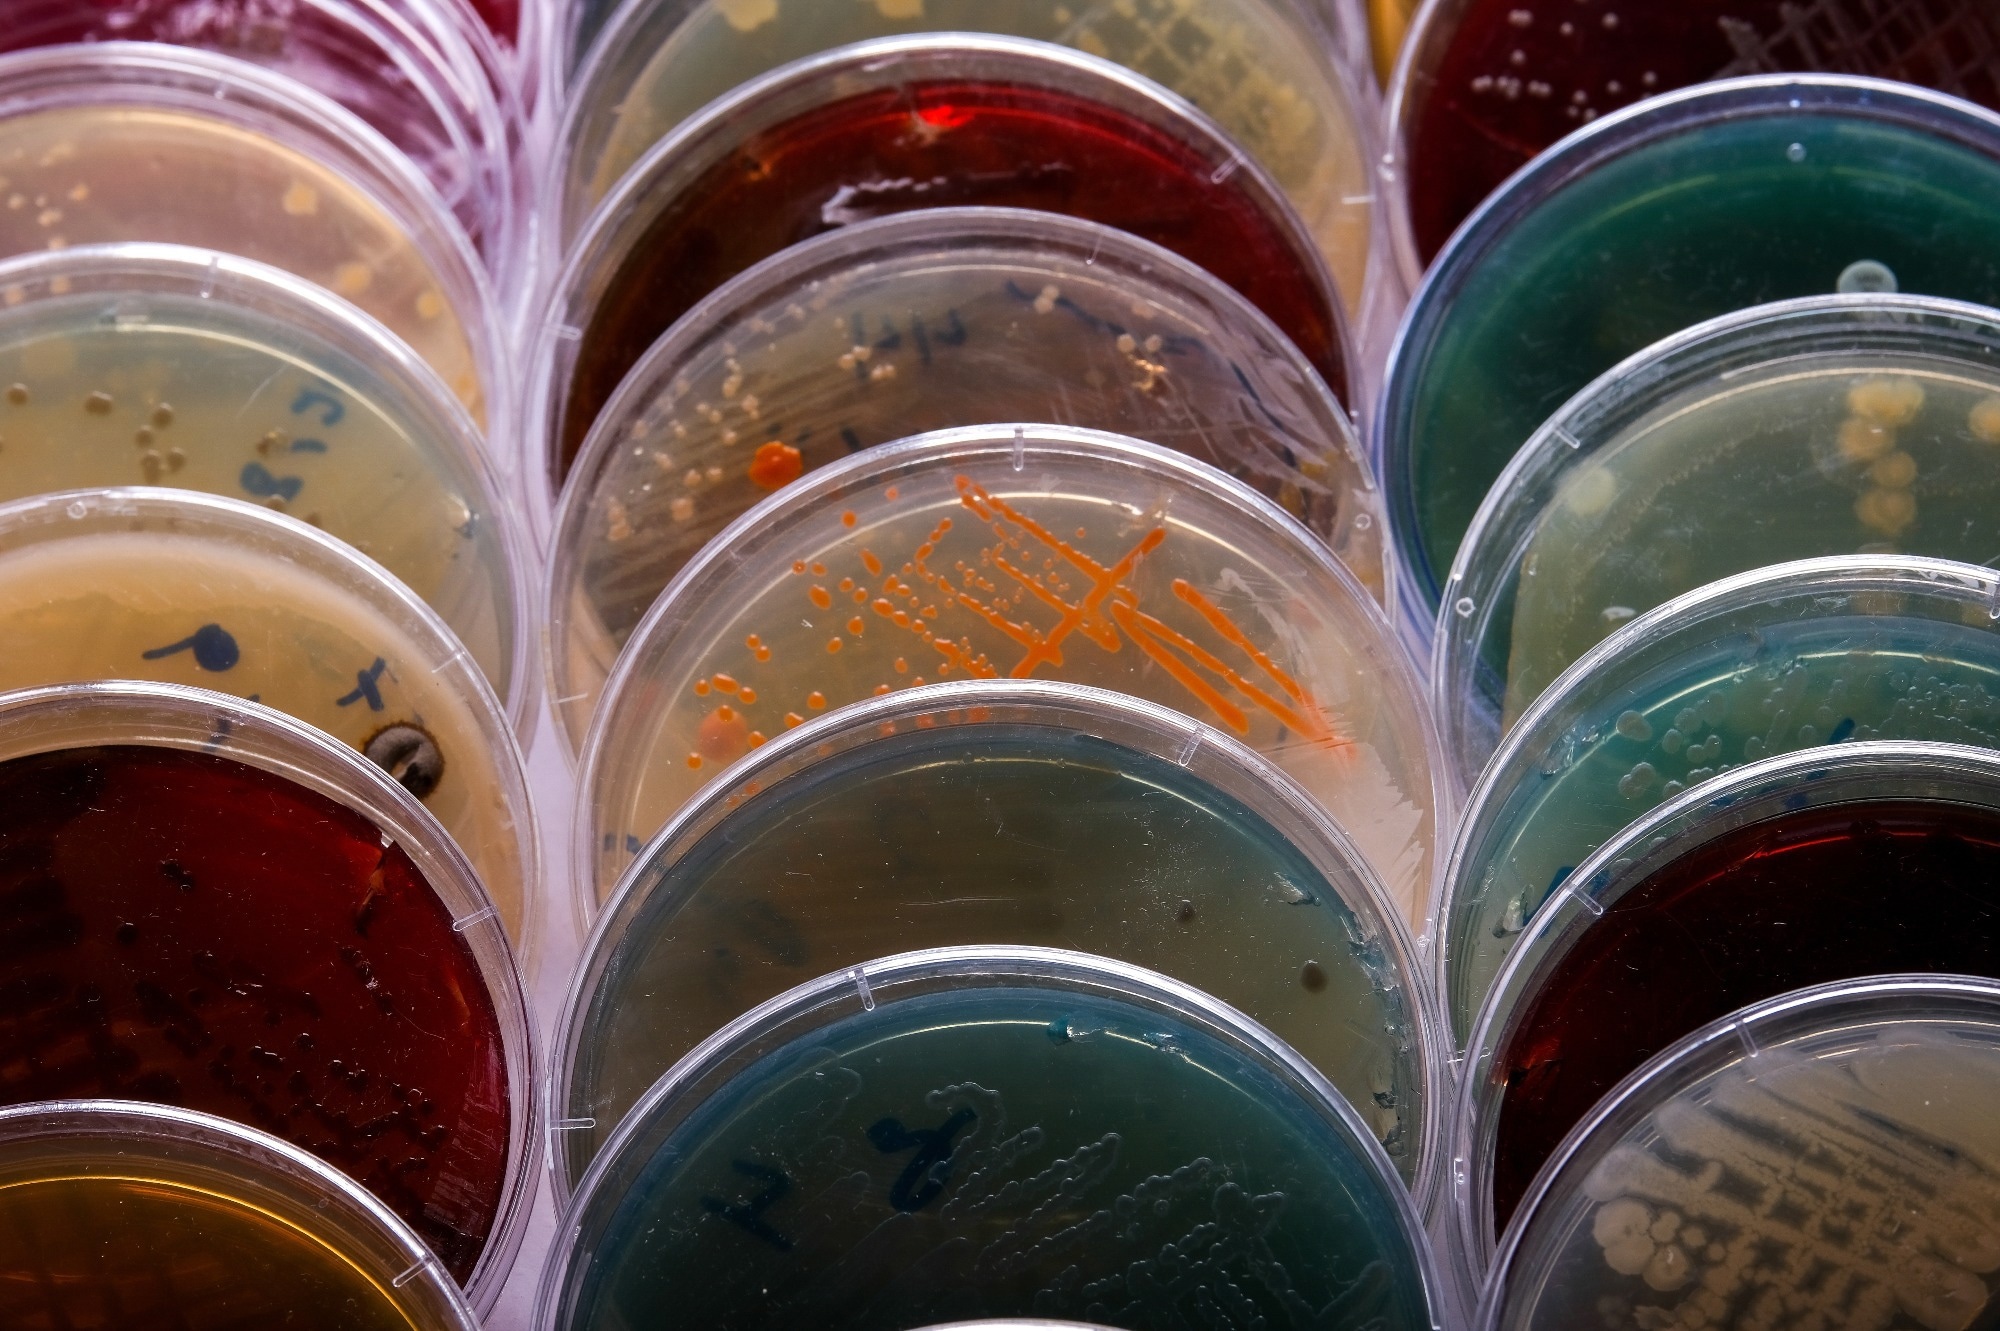
​​​​​​​Image Credit: Mohammed_Al_Ali/Shutterstock.com

A brief history of agar
Sources and chemical structure of agar
Properties of agar
Applications of agar in various fields
Biological Research
Conclusion
References
Further reading
Agar is a polysaccharide-based hydrocolloid synthesized in the cell walls of red seaweed, known as agarophytes.1 Owing to its unique gel-forming ability, agar has wide-ranging applications that include microbial media preparation, stabilizing agents, and the development of biodegradable food packaging films.
Image Credit: Mohammed_Al_Ali/Shutterstock.com
Image Credit: Mohammed_Al_Ali/Shutterstock.com
A brief history of agar
In the 17th century, a Japanese innkeeper named Tarozaemonminoya discovered agar by chance.2 During winter, he served a dish containing Gelidium spp (seaweed) to a high-ranked officer, and the uneaten food was found to transform into a white squashy material, eventually named agar.
Before World War II, Japan was the sole producer of agar, however, only small-scale industries produced them of inconsistent quality. In recent years, the use of modern technologies enabled a consistent production of high-quality agar.
Over the years, large-scale agar extraction from Gelidium sesquipedale seaweed and other processing steps have been significantly improved in Portugal and Spain.
During the end of the 19th century, agar was used beyond the food industry. For instance, it was used in the laboratory as media for bacterial growth which has immensely benefitted biotechnology-based industries. Seaweed was recognized as the "Medical Food of the Twenty-First Century".
Sources and chemical structure of agar
Agar is extracted from many species, namely, Gracilaria, Ceramium, Pterocladia, Gelidium, and Acantkopeltis. Among these agarophytes, G. acerosa is used to develop bacteriological grade agar and Gracilaria sp. for food quality agar.3
Agar occurs as a structural carbohydrate in its natural state and may exist in the form of its calcium salt, or a mixture of magnesium and calcium salts.2
Agar is a complex mixture of polysaccharides, namely, agarose and agaropectin. The ratio of agarose and agaropectin polymers varies in agar obtained from different seaweed species.4 Natural agar constitutes at least two-thirds of agarose.
Agarose is a natural polymer and is responsible for the gelling property. Chemically, it is sulfate-free chains of linear molecules that occur as repeating alternate units of β-1,3-linked- D-galactose and α-1,4-linked 3,6-anhydro-L-galactose.5
Agaropectin is the non-gelling fraction of agar. It is a charged polysaccharide that contains 3% to 10% sulfate, D-glucuronic acid, and small amounts of pyruvic acid. Agaropectin contains the same repeating units that of agarose, however, some 3,6-anhydro-L-galactose rings are replaced by L-galactose-6-sulphate, methoxy, or pyruvate groups. This chemical modification reduces its gelling capacity.6
Properties of agar
The wide-ranging applications of agar is due to its important structural and physical properties.7 Some of the key properties of agar are discussed below:
Gelling: The gelling capacity of agarose is associated with the presence of three equatorial hydrogen atoms on the 3,6-anhydro-L-galactose residues that constrain the polysaccharide molecule to form a helix. Double helices cluster together and form a three-dimensional structural network that can hold water molecules. Agar forms thermo-reversible gels, and the gel strength is influenced by the pH, concentration, and sugar content.
Solubility: Although agar is insoluble in cold water, it dissolves rapidly in boiling water. It is also soluble in many solvents at room temperature. It significantly swells by absorbing twenty times more than its weight of water.
Viscosity: The viscosity of agar solution varies in accordance with the raw material source.
Stability: The stability of agar depends on hydration and the charge. Prolonged exposure to high temperatures can lower gel strength.
Applications of agar in various fields
Agar is used in many fields including dentistry, food, microbiology-based laboratories, and biotech industries. Crude agar is processed to develop many textures, such as brittle, elastic, and solid, that are ideal for specific applications. Some of the key applications of agar are discussed below:
Food application
In the food industry, agar is typically used as gelling and stabilizing agents, and to control viscosity. It is only used as an additive and not as a nutrient. Since it is used in very low concentrations, the calorie contribution is negligible. Agar is used to prepare marmalade, jellies, and candies. In bakery, it is used to prevent dehydration of confectionery products.8
Food packaging materials
Many studies have highlighted the adverse health effects of plastic films used in food packaging. These adverse effects are linked with harmful chemicals (e.g., phthalates and bisphenol A (BPA)) that are released from plastic packings. Agar-based biodegradable food packaging films are transparent, non-toxic, and flexible, making them an ideal alternative to plastic food packaging films.9
Casting molds
Agar is used to prepare casting molds for sculpturing. Typically, glycerine is added to prevent cast dehydration because of its capacity to balance external humidity. It is also used to develop dental molds.2
Pharmacy
Agar is used in pharmacy as a thickening agent, suppository base (laxative), emulsifying agent, tablet binder, viscosity-increasing agent, stabilizing agent, and suspending agent. Pharmacists use agar to stabilize cholesterol solutions. In some cases, chemotherapeutics and antibiotics are loaded in composite hydrogel, and then slowly released.10
Photographic silkscreen
Agar extracted from Gelidium corneum is used in photographic silkscreen due to its superior durability, readability, and adaptability. Agar is better than branded emulsions because of its rapid processing capacity, low cost, and same printing outcome.2
Orchid nurseries
Agar is also used in plant tissue culture-based techniques to improve cellular cultivation. It helps grow virus-free clones of plants.
Biological research
In electrophoresis techniques, agarose gel is used to separate proteins.11 Microbiologists and biotechnologists use agar-based media to culture microorganisms, such as bacteria (nutrient agar) and potato dextrose agar (PDA). A broth media is solidified using agar, which supports the maintenance of pure culture and in growth behavior analysis. Nutrients in agar plates are easily accessible to microbes which aids in their rapid multiplication.
Conclusion
Agar, a polysaccharide-based hydrocolloid derived from red seaweed, has revolutionized various industries due to its unique gel-forming ability and versatile properties. Initially discovered in the 17th century, agar has transitioned from small-scale, inconsistent production to large-scale, high-quality manufacturing, particularly in Portugal and Spain.
Its chemical structure, comprising agarose and agaropectin, underpins its diverse applications. Agarose is responsible for the gelling properties crucial for microbial media preparation, while agaropectin's composition lends itself to other uses.
Agar’s applications span numerous fields, including food, where it serves as a stabilizer and gelling agent, and biodegradable food packaging, offering a sustainable alternative to plastics. In dentistry and sculpture, agar is used for casting molds, while in pharmacy, it functions as a thickening and stabilizing agent. It also plays a critical role in biological research, particularly in microbiology and biotechnology for culturing microorganisms.
The wide-ranging applications of agar underscore its importance as a multifunctional substance, making it invaluable in both industrial and scientific contexts. As research continues to explore and expand its uses, agar remains a key material across multiple disciplines.
References
- Belattmania Z, Bhaby S, Nadri A, et al. Gracilaria gracilis (Gracilariales, Rhodophyta) from Dakhla (Southern Moroccan Atlantic Coast) as Source of Agar: Content, Chemical Characteristics, and Gelling Properties. Mar Drugs. 2021;19(12):672.. doi:10.3390/md19120672
- Pandya HY, et al. Agar-agar extraction, structural properties and applications: A review. Pharma Innovation. 2022; 1(6): 1151-1157
- Vuai SAH. Characterization of agar extracted from Gracilaria species collected along Tanzanian coast. Heliyon. 2022;8(2):e09002. doi:10.1016/j.heliyon.2022.e09002
- Jönsson M, Allahgholi L, Sardari RRR, Hreggviðsson GO, Nordberg Karlsson E. Extraction and Modification of Macroalgal Polysaccharides for Current and Next-Generation Applications. Molecules. 2020;25(4):930.. doi:10.3390/molecules25040930
- Zucca P, Fernandez-Lafuente R, Sanjust E. Agarose and Its Derivatives as Supports for Enzyme Immobilization. Molecules. 2016;21(11):1577. doi:10.3390/molecules21111577
- Torres MD, Flórez-Fernández N, Domínguez H. Integral Utilization of Red Seaweed for Bioactive Production. Marine Drugs. 2019; 17(6):314. https://doi.org/10.3390/md17060314
- Villanueva, R.D., Sousa, A.M.M., Gonçalves, M.P. et al. Production and properties of agar from the invasive marine alga, Gracilaria vermiculophylla (Gracilariales, Rhodophyta). J Appl Phycol. 2019; 22, 211–220. https://doi.org/10.1007/s10811-009-9444-7
- Saha D, Bhattacharya S. Hydrocolloids as thickening and gelling agents in food: a critical review. J Food Sci Technol. 2010;47(6):587-597. doi:10.1007/s13197-010-0162-6
- Hernández V, Ibarra D, Triana JF, et al. Agar Biopolymer Films for Biodegradable Packaging: A Reference Dataset for Exploring the Limits of Mechanical Performance. Materials (Basel). 2022;15(11):3954. doi:10.3390/ma15113954
- Tang Y, Xu H, Wang X, et al. Advances in preparation and application of antibacterial hydrogels. J Nanobiotechnology. 2023;21(1):300. doi:10.1186/s12951-023-02025-8
- Greaser ML, Warren CM. Protein electrophoresis in agarose gels for separating high molecular weight proteins. Methods Mol Biol. 2012;869:111-118. doi:10.1007/978-1-61779-821-4_10
Further reading
Last Updated: Jul 10, 2024